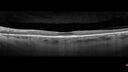
plaquenil1_105893_022121_06.jpg

Hydroxychloroquine Toxicity - Moderate
|
|
60 year old 140 lb female Decreased distance vision. She had an abnormal visual field. The patient was seen by a neuro-ophthalmologist and had a brain MRI and carotid ultrasounds which were normal. Then the patient was seen by a retina doctor in Tampa and was sent here (closer to where she lives). The patient had a migraine Arua in January 2021.
Medical Hx: Rheumatoid Arthritis
Systemic Meds: 400 mg/day PLAQUENIL FOR 15 YEARS stopped 3 months ago METHOTREXATE 10 MG. leucovorin 5 MG (as leucovorin calcium 5.4 MG) Oral Tablet. Estratab, 0.625 mg oral tablet. FOLIC ACID. FAMOTIDINE. VIT d3 2000. OMEGA 3 350MG. Celebrex 200 MG Oral Capsule
VA OD: sc20/40 PHNI NccJ3
VA OS: sc20/20 NccJ2
IOP: TP: OD:13 OS:11
Last images are 1 year after the initial images and show no progression off the plaquenil.
|

Hydroxychloroquine Toxicity102 views60 year old female received 6.5 mg/kg Plaquenil for 15 years and developed toxicity. VA 20/40 OD, 20/20 OS     (0 votes)
|
|

Hydroxychloroquine Toxicity134 views60 year old female received 6.5 mg/kg Plaquenil for 15 years and developed toxicity. VA 20/40 OD, 20/20 OS     (0 votes)
|
|

Hydroxychloroquine Toxicity123 views60 year old female received 6.5 mg/kg Plaquenil for 15 years and developed toxicity. VA 20/40 OD, 20/20 OS     (0 votes)
|
|

Hydroxychloroquine Toxicity92 views60 year old female received 6.5 mg/kg Plaquenil for 15 years and developed toxicity. VA 20/40 OD, 20/20 OS     (0 votes)
|
|

Hydroxychloroquine Toxicity96 views60 year old female received 6.5 mg/kg Plaquenil for 15 years and developed toxicity. VA 20/40 OD, 20/20 OS     (0 votes)
|
|
Hydroxychloroquine Toxicity104 views60 year old female received 6.5 mg/kg Plaquenil for 15 years and developed toxicity. VA 20/40 OD, 20/20 OS     (0 votes)
|
|

Hydroxychloroquine Toxicity115 views60 year old female received 6.5 mg/kg Plaquenil for 15 years and developed toxicity. VA 20/40 OD, 20/20 OS     (0 votes)
|
|

Hydroxychloroquine Toxicity116 views60 year old female received 6.5 mg/kg Plaquenil for 15 years and developed toxicity. VA 20/40 OD, 20/20 OS     (0 votes)
|
|

Hydroxychloroquine Toxicity118 views60 year old female received 6.5 mg/kg Plaquenil for 15 years and developed toxicity. VA 20/40 OD, 20/20 OS     (0 votes)
|
|

Hydroxychloroquine Toxicity90 views60 year old female received 6.5 mg/kg Plaquenil for 15 years and developed toxicity. VA 20/40 OD, 20/20 OS     (0 votes)
|
|
|
|
|
|
60 year old 140 lb female Decreased distance vision. She had an abnormal visual field. The patient was seen by a neuro-ophthalmologist and had a brain MRI and carotid ultrasounds which were normal. Then the patient was seen by a retina doctor in Tampa and was sent here (closer to where she lives). The patient had a migraine Arua in January 2021.
Medical Hx: Rheumatoid Arthritis
Systemic Meds: 400 mg/day PLAQUENIL FOR 15 YEARS stopped 3 months ago METHOTREXATE 10 MG. leucovorin 5 MG (as leucovorin calcium 5.4 MG) Oral Tablet. Estratab, 0.625 mg oral tablet. FOLIC ACID. FAMOTIDINE. VIT d3 2000. OMEGA 3 350MG. Celebrex 200 MG Oral Capsule
VA OD: sc20/40 PHNI NccJ3
VA OS: sc20/20 NccJ2
IOP: TP: OD:13 OS:11
Last images are 1 year after the initial images and show no progression off the plaquenil.